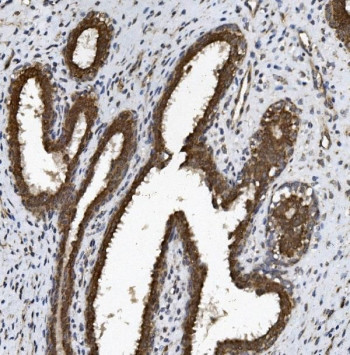
Anti-ABCG2 / BCRP

Cookie preferences
This website uses cookies, which are necessary for the technical operation of the website and are always set. Other cookies, which increase the comfort when using this website, are used for direct advertising or to facilitate interaction with other websites and social networks, are only set with your consent.
Configuration
Technically required
These cookies are necessary for the basic functions of the shop.
"Allow all cookies" cookie
"Decline all cookies" cookie
CSRF token
Cookie preferences
Currency change
Customer-specific caching
FACT-Finder tracking
Individual prices
Selected shop
Session
Comfort functions
These cookies are used to make the shopping experience even more appealing, for example for the recognition of the visitor.
Note
Show the facebook fanpage in the right blod sidebar
Statistics & Tracking
Affiliate program
Conversion and usertracking via Google Tag Manager
Track device being used
| Item number | Size | Datasheet | Manual | SDS | Delivery time | Quantity | Price |
|---|---|---|---|---|---|---|---|
| NSJ-RQ5697 | 100 µg | - | - |
3 - 10 business days* |
790.00€
|
If you have any questions, please use our Contact Form.
You can also order by e-mail: info@biomol.com
Larger quantity required? Request bulk
You can also order by e-mail: info@biomol.com
Larger quantity required? Request bulk
0.5mg/ml if reconstituted with 0.2ml sterile DI water. ABCG2 (Atp-binding cassette, subfamily g,... more
Product information "Anti-ABCG2 / BCRP"
0.5mg/ml if reconstituted with 0.2ml sterile DI water. ABCG2 (Atp-binding cassette, subfamily g, member 2) also known as ABCP, BCRP or MRX, is a protein that in humans is encoded by the ABCG2 gene. It is mapped on 4q22.1. The ABCG2 gene encodes a membrane transporter belonging to the ATP-binding cassette (ABC) superfamily of membrane transporters, which are involved in the trafficking of biologic molecules across cell membranes. The ABCG2 protein is also a high capacity transporter for uric acid excretion in the kidney, liver, and gut. In vitro assays of isolated membrane preparations revealed a high-capacity, vanadate-sensitive ATPase activity associated with ABCG2 expression that was stimulated by compounds known to be transported by this protein. ABCG2 is likely functioning as a homodimer or homooligomer in this expression system since it is unlikely that putative Sf9 transport partners would be overexpressed at similarly high levels. Abcg2 transports pheophorbide-a, which occurs in various plant-derived foods and food supplements and is highly efficient in limiting its uptake from ingested food. ABCG2 is a major factor in the concentrative transfer of drugs, carcinogens, and dietary toxins to the milk of mice, cows, and humans. Protein function: Broad substrate specificity ATP-dependent transporter of the ATP-binding cassette (ABC) family that actively extrudes a wide variety of physiological compounds, dietary toxins and xenobiotics from cells (PubMed:11306452, PubMed:12958161, PubMed:19506252, PubMed:20705604, PubMed:28554189, PubMed:30405239, PubMed:31003562). Involved in porphyrin homeostasis, mediating the export of protoporphyrin IX (PPIX) from both mitochondria to cytosol and cytosol to extracellular space, it also functions in the cellular export of heme (PubMed:20705604, PubMed:23189181). Also mediates the efflux of sphingosine-1-P from cells (PubMed:20110355). Acts as a urate exporter functioning in both renal and extrarenal urate excretion (PubMed:19506252, PubMed:20368174, PubMed:22132962, PubMed:31003562). In kidney, it also functions as a physiological exporter of the uremic toxin indoxyl sulfate. Also involved in the excretion of steroids like estrone 3- sulfate/E1S, 3beta-sulfooxy-androst-5-en-17-one/DHEAS, and other sulfate conjugates (PubMed:12682043, PubMed:28554189, PubMed:30405239). Mediates the secretion of the riboflavin and biotin vitamins into milk. Extrudes pheophorbide a, a phototoxic porphyrin catabolite of chlorophyll, reducing its bioavailability. Plays an important role in the exclusion of xenobiotics from the brain (Probable). It confers to cells a resistance to multiple drugs and other xenobiotics including mitoxantrone, pheophorbide, camptothecin, methotrexate, azidothymidine, and the anthracyclines daunorubicin and doxorubicin, through the control of their efflux (PubMed:11306452, PubMed:12477054, PubMed:15670731, PubMed:18056989, PubMed:31254042). In placenta, it limits the penetration of drugs from the maternal plasma into the fetus. May play a role in early stem cell self-renewal by blocking differentiation. [The UniProt Consortium]
| Keywords: | Anti-ABCP, Anti-ABCG2, Anti-CD338, Anti-CDw338, Anti-Urate exporter, Anti-Breast cancer resistance protein, Anti-ATP-binding cassette sub-family G member 2, Anti-Mitoxantrone resistance-associated protein, ABCG2 Antibody / BCRP |
| Supplier: | NSJ Bioreagents |
| Supplier-Nr: | RQ5697 |
Properties
| Application: | WB, IHC (paraffin), Direct ELISA |
| Antibody Type: | Polyclonal |
| Conjugate: | No |
| Host: | Rabbit |
| Species reactivity: | human, mouse, rat |
| Immunogen: | Recombinant human protein (amino acids M1-R378) |
| Format: | Purified |
Database Information
| KEGG ID : | K05681 | Matching products |
| UniProt ID : | Q9UNQ0 | Matching products |
| Gene ID : | GeneID 9429 | Matching products |
Handling & Safety
| Storage: | +4°C |
| Shipping: | +4°C (International: +4°C) |
Caution
Our products are for laboratory research use only: Not for administration to humans!
Our products are for laboratory research use only: Not for administration to humans!
Information about the product reference will follow.
more
You will get a certificate here
Viewed

